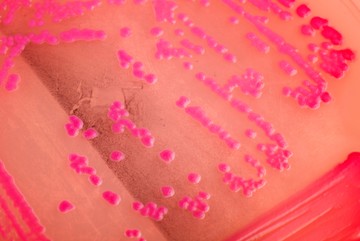

Újságírói pályámat belpolitikai újságírással, azon belül kiemelten fiatalokat, és az egészségügyet érintő területekkel kezdtem 1996-ban, az egykori Inform Média lapkiadónál; majd folytattam az utam hazai sajtóorgánumoknál, magazinoknál. Ahogy a print újságírás kibővült az online felületekkel, úgy tanultam bele az online újságírásba, marketingbe, egészségmenedzsmentbe, illetve a storeinsider.hu online főszerkesztőjeként az FMCG területek mélységeibe is. Egészségügyi érdeklődésem 2021-ben az Egészségkalauz.hu főszerkesztőjeként kötöttem össze a Ringier Hungary médiavállalattal.
Érdekel minden, ami javíthat az életminőségen, hiszek a folyamatos tanulásban, az életmódváltás, a természet, a gyógynövények erejében, de megbízni csak abban tudok, ami evidence based megállja a helyét, orvosilag is bizonyított. A ma emberének nem könnyű eligazodni a minket körül zsongó hírek, információk világában – csapatommal azon dolgozunk, hogy az Egészségkalauz olvasói az orvostudomány szűrőjén átvezetett, megbízható, hiteles egészségügyi információkhoz jussanak.
Hobbik:
- Belső kungfu; Tai Chi Chuan. A harci legyezőt forgatom a legszívesebben, a Yang stílusú legyezőforma áll a szívemhez legközelebb.
- Ékszerek. Büszke vagyok rá, hogy Reményi Katalin ötvös mester tanítványának fogadott, és szakmán kívüliként is egy kis ötvös tudományra okított. Fémből alkotni, mindig is szép kikapcsolódás, hobbi marad a számomra.
Legfrissebb cikkeim:

2025.04.13 13:09
Mi a hidrogén kilégzési teszt és mit mutat ki?

2025.04.13 13:08
Mi az ANA teszt és mit mutat ki?

2025.04.13 13:08
Mi a hasi röntgen és mit mutat ki?

2025.04.13 13:05
Mi az elektroneurográfia (ENG) és mit mutat ki?

2025.04.13 13:04
Mi a HPV teszt és mit mutat ki?
2025.04.13 13:03
Mi a mikrobiológiai tenyésztés és mit mutat ki?

2025.04.13 13:01
Mi a légúti allergiateszt és mit mutat ki?

2025.04.13 12:59
Mi a prosztata ultrahang és mit mutat ki?

2025.04.13 12:57
Mi a nőgyógyászati ultrahang és mit mutat ki?
